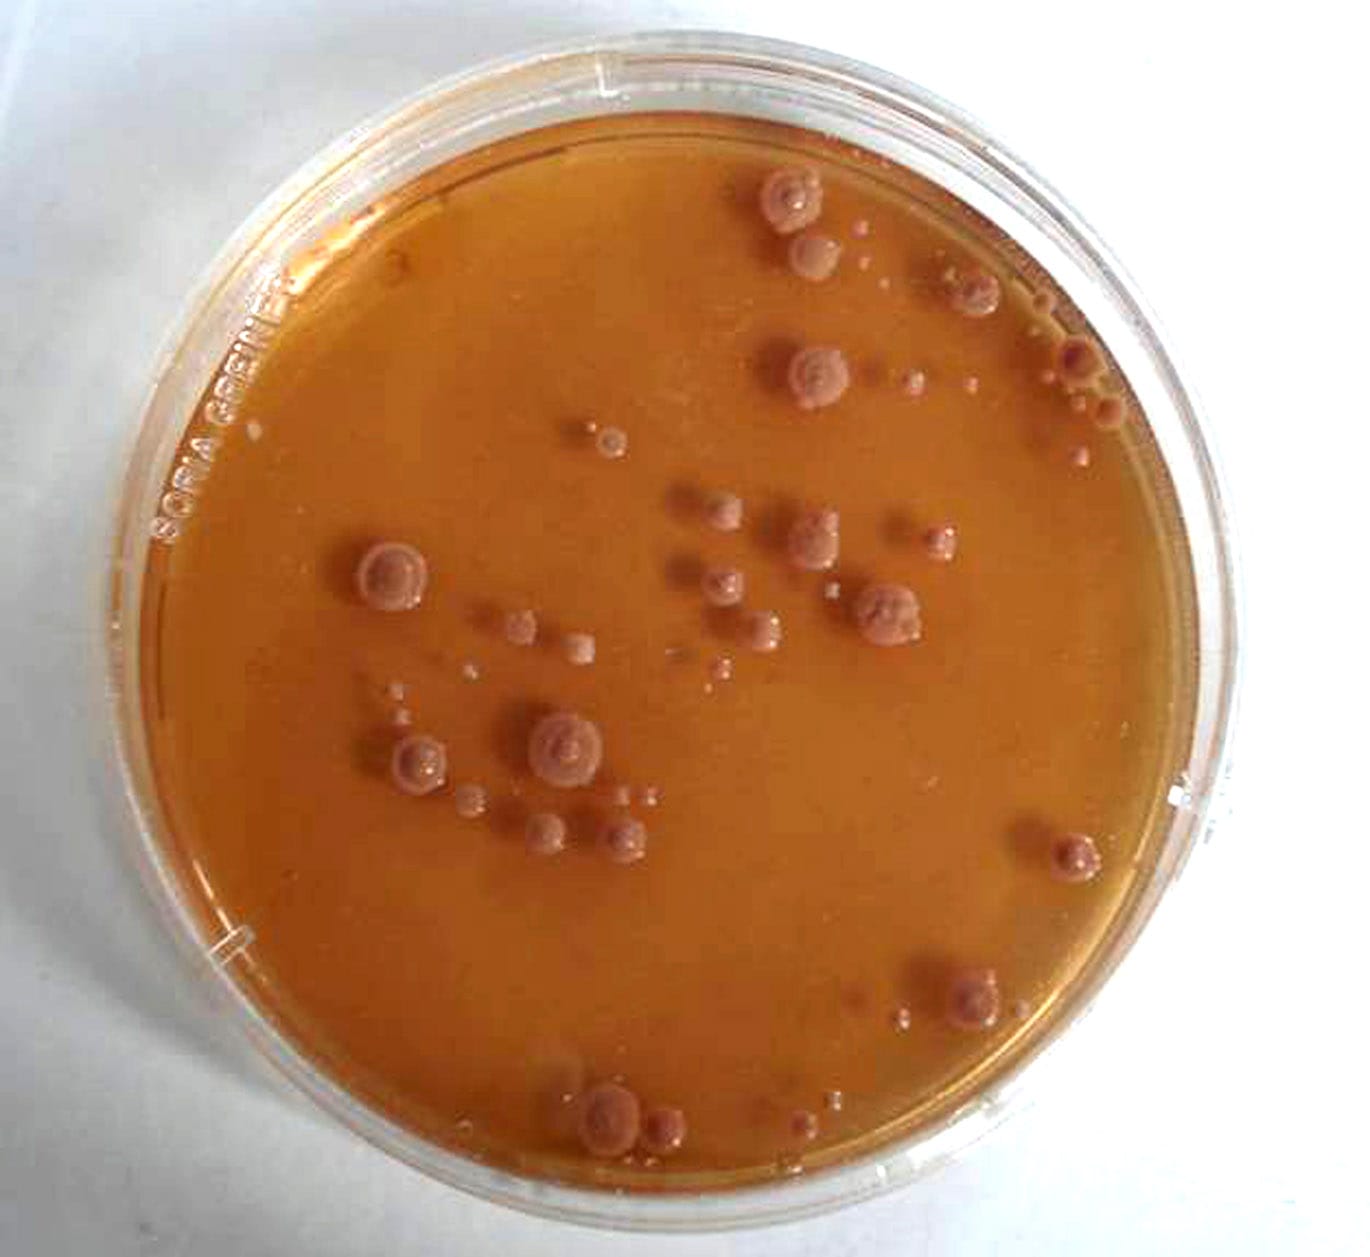

Fibromialgia. El huésped
En Patología infecciosa existen cuatro protagonistas de peso: 1) el huésped 2) el germen 3) el médico que lo identifica y 4) el fármaco que mata al mal bicho.
Un mal bicho burla las defensas del organismo y coloniza unos tejidos. El médico identifica la situación y aporta la ayuda necesaria para sacar del apuro al individuo. El individuo puede tener responsabilidad en facilitar la colonización pero, una vez producida esta, la evolución del problema está en manos del médico y la industria farmacéutica.
Este patrón define el marco de la Patología Infecciosa pero no todas las Patologías son así. Sin embargo muchos profesionales y padecientes actúan como si todo el monte fuera orégano infeccioso_._
En la Fibromialgia existe 1) el huesped u organismo 2) ¿? 3) ¿? 4) ¿?
El único protagonista claro es el 1: una padeciente que reside en un organismo rebosante de síntomas. Algo ha anidado en ese organismo, algo que genera dolor, cansancio, falta de concentración, desánimo, sueño desasosegado… Parece que tuviera que existir un equivalente al protagonista 2 de la Patología infecciosa, el germen, pero dicen que no hay tal sino que, en realidad, el germen es el propio huésped, el apartado 1: genes, traumas de infancia, estilos de vida… un organismo física y emocionalmente pusilánime que se ha venido abajo con los embates de la vida moderna.
La visita al médico en busca del apartado 3 (el diagnóstico) normalmente es infructuoso: propuestas confusas, funcionales, psicosomático, psicológico, «no tienes nada»… El apartado 3 remite también al apartado 1: el huésped. «Son cosas tuyas»…
El apartado 4, el de los remedios, tampoco resulta satisfactorio, al menos como acostumbra a serlo en las infecciones sensibles al antibiótico. Otra vez el fracaso de los remedios se carga en la cuenta del apartado 1: el huésped, quien padece la situación: «Tienes que poner de tu parte»…
La Fibromialgia es una enfermedad con un sólo apartado bien definido: el huésped, el organismo sensible a ser sensibilizado.
Eso parece pero…
Supongamos que la cultura, la información actúe como un germen y que el huésped sea el cerebro, el órgano de las virtualidades, de los mundos imaginados. Tendríamos:
- El cerebro como huésped. 2) La cultura como germen 3) el médico como identificador de ese germen 4) la pedagogía como antídoto.
– O sea que soy YO la responsable de la enfermedad. ¿El dolor me lo provoco YO? ¿Es imaginario?
– En absoluto. El YO no es el huésped. Realmente no sabemos muy bien lo que es. La conciencia, el ámbito en el que se produce la percatación de ser un organismo, es un universo misterioso. El huésped, el terreno abonado, es su cerebro. El YO ha formado parte más o menos consciente de la preparación de ese terreno pero cuando afloran los síntomas es porque al huésped, al cerebro, le desbordan los miedos somáticos, el miedo al daño físico y social, a las carencias frente a la penosidad, la convicción de poca valía física y psicológica, de virulencia ambiental… El YO tiene que tomar consciencia de ello y volver la mirada hacia su cerebro, no para resonar los errores, para amplificarlos, sino para disolverlos. El antibiótico es la convicción de salud y la firmeza en la decisión de recuperar el terreno perdido.
Creerse enfermo o sano. Esa es la cuestión
Comentarios (6)
Los comentarios están cerrados.